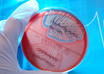

Dementia linked with COVID-related death in large study
IANS | Dec 22, 2022
Three cases of BF.7 variant found in India so far
IANS | Dec 22, 2022
Loss of smell most prevalent symptom of long COVID: Study
PTI | Dec 22, 2022
Smoking raises risk of midlife memory loss, confusion
ANI | Dec 22, 2022
Child body weight has limited effect on mood, behavioural issues: Study
ANI | Dec 21, 2022
Biodegradable medical gowns generate hazardous pollutants: Research
ANI | Dec 21, 2022
Increased pharmaceuticals use spiked carbon emissions during pandemic
IANS | Dec 21, 2022
Most read this week